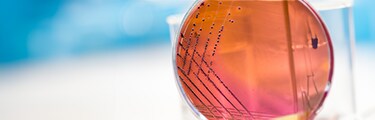
Auswahl kompetenter Zellen von Invitrogen™ je nach Anwendung Auswahl kompetenter Zellen von Invitrogen™ je nach Anwendung

Entdecken Sie unser ausgewähltes Sortiment an hochmodernen E. coli-Transformationsprodukten, wie z. B. kompetente Zellen, die exklusiv für wissenschaftliche Labors entwickelt wurden. Die E. coli-Transformation ist eine grundlegende Technik in der Gentechnik und Molekularbiologie. Einige gängige Methoden, die seit den 1980er Jahren verfeinert wurden, sind die chemische Transformation mit Kalziumchlorid, die Elektroporation (Einbringen von DNA durch elektrische Impulse) und der Hitzeschock. Ob Sie nun Gen-Knockout-Experimente, die Herstellung rekombinanter Proteine oder die Untersuchung der Genregulation anstreben, unsere Auswahl an E. coli-Transformationsprodukten wird Sie bei Ihren Bemühungen unterstützen.
Weitere Produkte
Ähnliche Ressourcen
Bedingungen und Konditionen für diese Aktion.
Dieses Angebot gilt nur für Kunden in Belgien, Dänemark, Deutschland, Finnland, Frankreich, Großbritannien, Irland, Italien, Luxemburg, Norwegen, Österreich, Schweden, Schweiz, Spanien und den Niederlanden. Das Angebot gilt nur für qualifizierte Bestellungen, die zwischen Dienstag, dem 5. September, und Freitag, dem 15. Dezember 2023, 23:59 Uhr MESZ, bei Thermo Fisher Scientific eingehen, oder bis der Vorrat an Aktionsprodukten aufgebraucht ist, je nachdem, was zuerst eintritt. Um den Rabatt zu erhalten, müssen Kunden den oben angegebenen Aktionscode (21275) angeben. Dieser muss bei der Bestellung angegeben werden, um den Rabatt zu erhalten. Der Aktionscode kann mehr als einmal verwendet werden. Eine Liste der in Frage kommenden Produkte finden Sie auf dieser Seite. Das Angebot ist nur auf qualifizierte Produkte beschränkt. Dieses Angebot kann nicht mit anderen Rabatten oder Aktionen kombiniert werden. Das Angebot ist ungültig, wenn es durch Bundes-, Landes-, Provinz- oder lokale Gesetze oder Vorschriften oder Richtlinien von Agenturen/Institutionen verboten, lizenziert oder eingeschränkt ist. Es können weitere Einschränkungen gelten.
Zurück nach oben